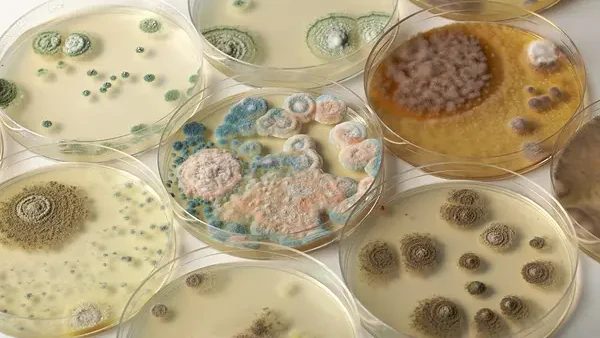
микотоксины

Опасность микотоксинов и роль экспресс-тестов в их обнаружении | |
|
Экспресс-тесты на микотоксины — быстрый, удобный и надёжный способ контролировать безопасность зерна, кормов и продуктов питания.
Микотоксины — это токсичные вещества, которые вырабатывают определённые виды плесневых грибов, поражающих зерно, орехи, семена, корм и другие продукты. Даже при небольших концентрациях они могут представлять серьёзную угрозу здоровью человека и животных: вызывать отравления, снижать иммунитет, влиять на работу печени и почек, нарушать обмен веществ. Проблема в том, что микотоксины устойчивы к высоким температурам и не разрушаются при обычной термической обработке. Поэтому важно выявлять их еще на этапе сырья или сразу после производства. Чтобы сделать тест микотоксины нужно использовать проверенные инструменты, купленные у надежной компании. Почему экспресс-тесты на микотоксины стали популярными?Современные предприятия всё чаще используют иммунохроматографические тест-полоски и наборы для экспресс-анализа микотоксинов. Эти тесты позволяют быстро и с высокой точностью определить наличие опасных соединений прямо на месте — в зернохранилище, на элеваторе, в лаборатории или даже в полевых условиях.
Преимущества тестов на микотоксиныК ним отнести можно:
Где применяются тесты на микотоксиныСреди основных сфер применения отметить можно:
Экспресс-тесты на микотоксины — это быстрый, удобный и надёжный способ контролировать безопасность зерна, кормов и продуктов питания. Они позволяют выявить опасные вещества ещё до того, как продукция попадёт на переработку или в торговую сеть, минимизируя риск для здоровья и финансовые потери. Предварительные консультации, если для покупки обратиться в проверенную компанию, помогут разобраться в тонкостях и видах тестов, сделать верный выбор. Также рассчитывать можно на гарантированное качество вместе с точностью. | |
| 15.08.2025 в 19:30 | |
| Комментариев нет. |
|